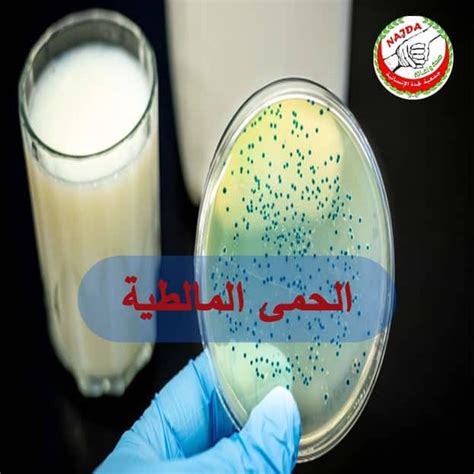

هل الدوسنتاريا معدية هناك العديد من المشاكل والأمراض التي تصيب الجهاز الهضمي ومنها الزحار الذي يصيب الأمعاء وخاصة الأمعاء الغليظة ويرافقه إسهال مخاطي شديد أو دموي وهو مرض معد.
تستمر أعراض الدوسنتاريا لمدة ثلاثة أيام ثم تختفي، ولكن في بعض الحالات تحدث الوفاة بسبب الجفاف الذي يصيب الجسم ولا يتم تعويضه بالسوائل.
جدول المحتويات
- هل الإسهال معدي؟
- احذر من الطعام الملوث
- شلالات الرور (سهلة، متوسطة، صعبة)
- أعراض طفيفة
- أعراض معتدلة
- حالات سيئة
- أنواع الزحار
- الزحار البكتيري
- الزحار الأميبي
- أعراض الزحار
- أعراض الزحار الذي تسببه بكتيريا الشيكيلا
- أعراض الزحار الناجم عن الأميبا
- عواقب عدم علاج الزحار
- جفاف
- التهاب المفاصل المعدي
- التهاب مجرى الدم
- تشنجات
- متلازمة انحلال الدم اليوريمي
- الحماية من الزحار
- علاج الزحار بالأعشاب الطبيعية
- بعض الاحتياطات اللازمة لتقليل العدوى
هل الإسهال معدي؟

- تعرف منظمة الصحة العالمية الزحار على أنه نوبة إسهال مستمرة يختلط فيها الدم بالبراز.
- ينتقل بشكل رئيسي بين الناس عن طريق المياه والغذاء الملوثين.
- يعيش الطفيل Entamoeba histolytica، العامل المعدي، في القناة الهضمية، ويستقر في القولون، ويتغذى على الغشاء المخاطي الذي يبطنه.
- إحداث ثقوب في هذا الغشاء وتحليلها بفضل الإنزيمات التي يفرزها هذا الطفيل.
- ينتقل في براز الشخص المصاب، ويمكن أن ينتقل المرض من الحيوانات إلى الإنسان.
- لأن الزحار مرض معد، يقع العديد من المرضى ضحية له، سواء في المنزل أو في رياض الأطفال أو في المدرسة أو في العمل أو في الأماكن المزدحمة.
انظر أيضًا: معلومات طبية لعلاج الزحار
احذر من الطعام الملوث

- ينتقل الزحار عن طريق الصراصير والذباب المنزلي، وتحدث العدوى من خلال دخول براز الشخص المصاب إلى الفم.
- عند تناول الطعام الملوث نجد أنه يحتوي على كيس طفيلي الأميبا.
- أو عن طريق الذباب الذي يقف على هذه الفضلات وينقله إلى المشروبات والأطعمة أو يقف على أفواه الأطفال.
- السباحة في المياه الملوثة والبرك هي أيضًا أحد أسباب الإصابة بالدوسنتاريا
شلالات الرور (سهلة، متوسطة، صعبة)

ينتشر الزحار في المناطق الحارة والاستوائية في حالات:
أعراض طفيفة

- تستمر الأعراض من 5 إلى 7 أيام، وتكون الأعراض خفيفة وتتمثل في الإسهال والمخاط والدم في البراز والتهاب القولون والغثيان والقيء.
أعراض معتدلة

- إسهال من 3 إلى 4 مرات في اليوم، براز لزج، مخاطي، مع شعور بالتعب، وتشنجات، وغازات كثيفة، وفقدان للوزن.
- للعطش الشديد، قلة التبول، فقدان القوة وتشنجات العضلات.
حالات سيئة

- الإسهال شديد وتتراوح مستوياته من 10 إلى 20 مرة في اليوم مع وجود دم في البراز وحمى وقيء وأوجاع وآلام في البطن.
- في بعض الحالات النادرة، يمكن أن يشكل الجفاف الناجم عن الإسهال تهديدًا حقيقيًا للحياة.
- في حالة حدوث أي تغيير مفاجئ في السلوك مثل الخمول والأوهام والهذيان والارتباك والأوهام، اطلب العناية الطبية على الفور.
- دوار شديد، دوار، ضربات قلب سريعة وغير منتظمة، ارتفاع شديد في درجة حرارة الجسم.
أنواع الزحار

هناك نوعان رئيسيان من الزحار:
- الزحار البكتيري.
- والدوسنتاريا الأميرية.
الزحار البكتيري

- تشمل البكتيريا (Enterobacillus و Salmonella و Campylobacter و Shigella، وهي الأكثر شيوعًا)
الزحار الأميبي

- وهو طفيلي وحيد الخلية يصيب الأمعاء وهو أقل شيوعًا من الزحار البكتيري.
- يحدث الزحار الأميبي بشكل رئيسي في الأشخاص الذين سافروا إلى مناطق موبوءة مثل جنوب شرق آسيا والدول الأفريقية.
اقرأ أيضًا: عن الأمراض التي تنتقل عن طريق الذباب المنزلي
أعراض الزحار

- ينتج الزحار عن عدوى بكتيرية تسببها بكتيريا الشيخيلة أو عدوى أميبية بسبب نوع من الأميبا.
- أو أسباب أخرى مثل الفيروسات والديدان الطفيلية.
- تظهر الأعراض عادة بعد يوم إلى ثلاثة أيام من الإصابة، وقد لا تظهر أي أعراض على بعض الأشخاص.
أعراض الزحار الذي تسببه بكتيريا الشيكيلا
عادة ما تكون الأعراض خفيفة وتتمثل في الإسهال وألم في البطن، ولكن هذه الأعراض يمكن أن تزيد وتسبب:
- استفراغ و غثيان.
- درجة حرارة عالية؛
- تقلصات المعدة.
- الإسهال المخاطي أو الدموي
أعراض الزحار الناجم عن الأميبا

- التعب العام
- وجود الألم أثناء عملية الإقصاء.
- إسهال مائي مع مخاط أو دم.
- استفراغ و غثيان.
- الهزات وارتفاع درجة الحرارة.
- آلام في المعدة.
- في بعض الحالات النادرة، تنتشر الأميبا عبر الدم، وخاصة الكبد، مسببة خراج الكبد.
عواقب عدم علاج الزحار

يمكن أن تزداد أعراض الزحار سوءًا لدرجة أنك تحتاج إلى زيارة الطبيب والمعالجة، وتشمل هذه الأعراض:
جفاف

- الإسهال المتكرر والقيء يؤديان إلى الجفاف الذي قد يودي بحياة الأطفال والرضع.
التهاب المفاصل المعدي

- يمكن أن يصاب 2 ٪ من الأشخاص بالتهاب المفاصل الروماتويدي بعد الإصابة بجرثومة الزحار الشيغيلا.
- تشمل الأعراض المصاحبة للتبول تهيج العين وآلام المفاصل، وتستمر الأعراض من شهور إلى سنوات.
التهاب مجرى الدم

- وهي حالات نادرة تصيب مرضى السرطان والإيدز بسبب ضعف مناعتهم.
تشنجات

- لا يوجد سبب محدد لهذه التشنجات، والتي تصيب أحيانًا الأطفال المصابين بالدوسنتاريا.
متلازمة انحلال الدم اليوريمي

- تحدث هذه المتلازمة بسبب بكتيريا الشيغيلا، وفي بعض الأحيان تنتج هذه البكتيريا سمومًا تكسر خلايا الدم الحمراء.
الحماية من الزحار

ينتقل الزحار بعدة طرق، بما في ذلك الطعام الملوث والمياه الملوثة وإهمال النظافة الشخصية، مثل ب- عدم غسل يديك بعد الذهاب إلى المرحاض.
إذا كنت تعيش في أماكن تعاني من الزحار، فيجب عليك القيام بما يلي:
- لا تشارك الأغراض الشخصية مع الآخرين.
- اغسل يديك باستمرار بالماء والصابون.
- لا تأكل طعام الشارع.
- تناول الطعام المطبوخ جيدًا.
- اغسل أسنانك بانتظام واستخدم المياه المعدنية بدلاً من مياه الصنبور.
علاج الزحار بالأعشاب الطبيعية

أثبتت العلاجات البديلة نفسها في الممارسة العملية، وتشمل هذه الأعشاب:
- اخلطي كميتين متساويتين من الكركم والحبة السوداء واخلطيهما مع العسل وخذي ملعقة كبيرة من هذا الخليط قبل الإفطار.
- يخلط السماق بالعسل ويؤكل ثلاث مرات يوميا حتى الشفاء.
- امزج 15 جرامًا من الشعيرية الهندية و 5 جرام من المر و 5 جرام من الزنجبيل.
- ثم يُطحن هذا المزيج ويغلى في نصف لتر من الماء ويؤخذ مرتين في اليوم بعد التحلية بالعسل لمدة 5 أيام.
- امزج مقادير متساوية من الزنجبيل والقرنفل والقرفة والزبيب الأسود في عجينة وتناول ملعقة كبيرة يوميًا قبل الإفطار لمدة أسبوعين.
- اشرب قشر الرمان المطبوخ المحلى بالعسل أربع مرات في اليوم حتى يتعافى تماما.
- يمكن استخدام سلطة الفاكهة المصنوعة من الجوافة والرمان والأناناس والتفاح والموز وغيرها من الفواكه الطازجة لعلاج الزحار.
- يتناول المريض 4 فصوص ثوم و 4 حبات بطاطس لمدة أسبوع.
- امزج عصير الليمون مع بياض البيض وخذ 3 أيام بعد الإفطار حتى يتم التخلص من المخاط تدريجيًا حتى ظهور حركات الأمعاء الطبيعية.
اقرأ أيضًا: فوائد الرمان الحامض
بعض الاحتياطات اللازمة لتقليل العدوى

هناك عدد من الاحتياطات الضرورية التي من شأنها أن تساعد في الحد من حدوث الزحار، ومنها:
- يجب غسل اليدين بشكل متكرر طوال اليوم بعد استخدام المرحاض وبعد ملامسة شخص مصاب.
- اغسل يديك قبل تحضير الطعام وقبل الأكل وقبل التعامل مع الأطفال.
- إطعام كبار السن والشباب بشكل جيد.
- الحد من الاتصال بشخص معروف بإصابته بالدوسنتاريا.
- انتبه للنظافة الشخصية ولا تشارك بعض العناصر مثل الملابس والمناشف مع الآخرين.
- اغسل الخضار والفاكهة جيدًا.
- تخلص من الذباب واحتفظ بحساب التغوط مفتوحًا.
- التدقيق الصحي للطهاة وعمال المطاعم والأسر.
- قم بتغطية القمامة والتخلص منها في الأماكن المخصصة لها في أسرع وقت ممكن.
- لا تشرب الماء أو تأكل الخضار والفواكه ذات النظافة المشكوك فيها عند السفر إلى بلد لا يفي بمتطلبات الأمن الصحي، واستشر الطبيب قبل السفر ليقرر لك ما هي الأدوية التي تتناولها في تلك الدولة التي تحتاجها.
هل الزحار معدي، ويسمى أيضًا الزحار، وهو التهاب معوي مصحوب بإسهال شديد وبراز مصحوب بدم أو مخاط نتيجة لقرحة القولون.
يصيب هذا المرض الأطفال والمراهقين في الدول النامية ويمكن أن يسبب هذا المرض الجفاف الذي يؤدي بدوره إلى الوفاة في بعض الحالات.